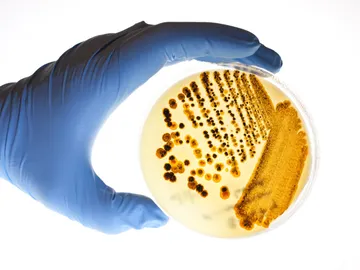

Astronomía, divulgación, descubrimientos, ecología, innovación...

La polipíldora española reduce en un 33 % la mortalidad cardiovascular en recaídas por infarto
Un medicamento efectivo contra más de 300 bacterias resistentes a los fármacos

Investigan un medicamento que permitiría vivir hasta los 200 años

Encuentran un fármaco más efectivo para tratar el accidente cerebrovascular isquémico agudo

Más cerca de la píldora anticonceptiva para hombres

Así es Olumiant, el fármaco contra la alopecia areata aprobado en Estados Unidos

Sanidad retira un conocido medicamento para el colesterol

Cómo funciona Saxenda, el medicamento inyectable para adelgazar

Qué medicamentos o sustancias pueden subir la presión arterial

Las cinco bebidas con las que jamás debes tomarte tus medicamentos

La razón por la que es casi imposible volver a doblar un prospecto

Por qué algunos medicamentos se pueden tomar con el estómago vacío y otros no

Desarrollan un analgésico tan potente como la morfina pero sin sus efectos secundarios
